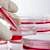

Beyin hücrelerinde saptanan hasarlı DNA, Parkinson tedavisinde devrim yaratabilir

Yeni yayımlanan bir araştırmanın bulguları, Parkinson hastalığının tanı ve tedavisini tamamen değiştirebilir. Kopenhag Üniversitesi’ndeki araştırmacılar, beyin hücrelerindeki mitokondriyal DNA’daki hasarın Parkinson hastalığını tetikleyerek yayılmasına neden olduğunu keşfetti. Kandaki hasarlı mitokondriyal DNA’nın tespiti, Parkinson hastalığı için erken bir biyo-belirteç olabilir; daha iyi teşhis ve tedavi umudu sunabilir. Çalışmanın yazarlarına göre, beyin hücrelerindeki hasarlı mitokondriyal DNA parçaları hücrenin içine salınarak toksik hale geliyor ve komşu hücrelere yayılarak hastalığın ilerlemesine neden oluyor.
The Lancet Microbe dergisinde yayınlanan bulgular, hasar görmüş mitokondriyal DNA’nın (mtDNA) yalnızca Parkinson hastalığını başlatmakla kalmayıp aynı zamanda beyinde yayılmasına da yol açabileceğini gösteriyor.
Parkinson Hastalığının Çözümü Olarak Beyindeki Hasarlı DNA
Dünya genelinde 10 milyondan fazla insanı etkileyen ciddi bir kronik hastalık olan Parkinson nedenleri konusunda bu güne kadar pek çok farklı tez bulunuyordu. Yaygın kabul gören kanı hastalığın büyük ölçüde ailevi genetik faktörler ile ilişkili olduğu yönündeydi. Ancak, Parkinson Hastalığı vakalarının çoğunluğunun nedenleri belirsizdi. Yeni araştırmanın bulguları bu alandaki anlayışı önemli oranda değiştirebilir.
Çalışmanın baş yazarı Kopenhag Üniversitesi’nden Prof. Dr. Shohreh Issazadeh-Navikas liderliğindeki ekip, beyin hücrelerindeki temel enerji üreticileri olan mitokondri, DNA’larında oluşan hasarın hastalığın gelişmesinde çok önemli bir faktör olduğunu saptadılar. Prof. Dr. Shohreh Issazadeh-Navikas, elde ettikleri sonuçlarla ilgili şu değerlendirmeyi yapıyor:
“İlk kez, beyin hücrelerinde, özellikle de nöronlarda hayati enerji üreten mitokondrilerin hasara uğradığını ve mitokondriyal DNA’da bozulmalara yol açtığını gösterebildik. Bu, hastalığı başlatıp kontrolsüz bir orman yangını gibi beyinde yayılmasına neden oluyor. Bulgular, hasarlı genetik materyal olan mitokondriyal DNA’nın yayılmasının, Parkinson hastalığının semptomlarına ve bunun ise demansa ilerlemesine neden olduğunu ortaya koyuyor.”

Prof. Dr. Shohreh Issazadeh-Navikas
Araştırmacılar, insan ve fare beyinlerini inceleyerek, beyin hücrelerindeki mitokondri hasarının, bu hücrelerin anti-viral tepki genlerinde kusurlar olduğunda daha da kötüleştiğini tespit etti. Sonuç olarak, bu hasarlı DNA’nın küçük parçaları hücrenin içine salınarak toksik hale geliyor.
Araştırmanın potansiyel klinik sonuçları çok önemli
Prof. Dr. Issazadeh-Navikas, bu zehirli DNA parçalarının yayılmasını “küçük bir kıvılcımın yol açtığı kontrolsüz bir orman yangınına” benzetiyor. Bu parçalar komşu ve hatta uzak beyin hücrelerine hareket ederek hastalığın daha da yayılmasına neden oluyor. Bu araştırmanın dikkate değer en önemli yanlarından birisinin olası potansiyel klinik sonuçları olduğunu belirten Prof. Dr. Issazadeh-Navikas, “Hasarlı mtDNA kanda tespit edilebilirse, bu hastalık için erken bir biyo-belirteç işlevi görebilir. Bu, erken teşhis, hastalık takibi ve hatta ilaç geliştirme konusunda devrim yaratacaktır” diyor.
Parkinson tedavisi: En etkili yöntemler ve hastalara öneriler
Ekip, kan dolaşımında hasarlı mtDNA’nın tespit edilebilmesi olasılığından umutlu ve bu durumun hastalığın teşhisi, izlenmesi ve yeni Parkinson tedavi seçeneklerinin geliştirilmesinde devrim yaratacağını düşünüyor. Ayrıca araştırma potansiyel tedavi stratejilerine de işaret ediyor. Normal mitokondriyal işlevi geri yükleyerek hastalıkta rol oynayan mitokondriyal işlev bozukluklarını gidermek mümkün olabilir.
Araştırma, Avrupa Birliği’nin Horizon 2020 Araştırma ve Yenilik Programı, Lundbeck Vakfı ve Danimarka Bağımsız Araştırma-Tıp Konseyi gibi kurumlar tarafından desteklenmiş.
Araştırmanın Özeti
Mitochondrial DNA damage triggers spread of Parkinson’s disease-like pathology
Abstract: In the field of neurodegenerative diseases, especially sporadic Parkinson’s disease (sPD) with dementia (sPDD), the question of how the disease starts and spreads in the brain remains central. While prion-like proteins have been designated as a culprit, recent studies suggest the involvement of additional factors. We found that oxidative stress, damaged DNA binding, cytosolic DNA sensing, and Toll-Like Receptor (TLR)4/9 activation pathways are strongly associated with the sPDD transcriptome, which has dysregulated type I Interferon (IFN) signaling.
Parkinson tedavisinde beyin pili yöntemi hastanın yaşam kalitesini yükseltiyor
In sPD patients, we confirmed deletions of mitochondrial (mt)DNA in the medial frontal gyrus, suggesting a potential role of damaged mtDNA in the disease pathophysiology. To explore its contribution to pathology, we used spontaneous models of sPDD caused by deletion of type I IFN signaling (Ifnb–/–/Ifnar–/– mice). We found that the lack of neuronal IFNβ/IFNAR leads to oxidization, mutation, and deletion in mtDNA, which is subsequently released outside the neurons. Injecting damaged mtDNA into mouse brain induced PDD-like behavioral symptoms, including neuropsychiatric, motor, and cognitive impairments. Furthermore, it caused neurodegeneration in brain regions distant from the injection site, suggesting that damaged mtDNA triggers spread of PDD characteristics in an “infectious-like” manner.
Kaynaklar ve Referanslar:
1- Discovery of Damaged DNA in the Brain Could Be the Key to Solving Parkinson's DiseaseYAZIYI PAYLAŞ

Yeni genetik biobelirteç Alzheimer teşhisinde devrim yaratabilir
Yeni genetik biobelirteç Alzheimer teşhisinde devrim yaratabilir Parkinson hastalığı neden olur? Belirtileri ve tedavisi
Parkinson hastalığı neden olur? Belirtileri ve tedavisi Parkinson sadece yaşlılık hastalığı değildir, gençlerde de görülebilir
Parkinson sadece yaşlılık hastalığı değildir, gençlerde de görülebilir Parkinson tedavisinde beyin pili yöntemi hastanın yaşam kalitesini yükseltiyor
Parkinson tedavisinde beyin pili yöntemi hastanın yaşam kalitesini yükseltiyor Parkinson tedavisi: En etkili yöntemler ve hastalara öneriler
Parkinson tedavisi: En etkili yöntemler ve hastalara öneriler
YORUMUNUZ VAR MI?